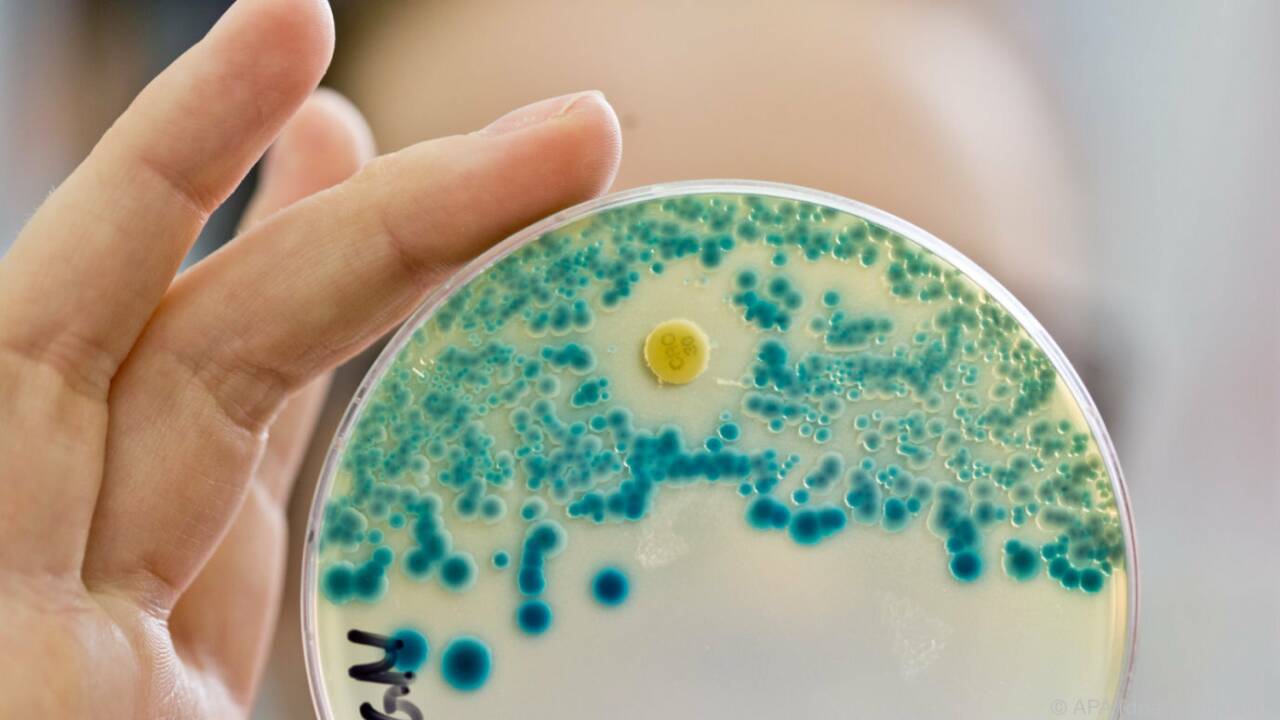
Resistente Bakterien können zum Problem werden. (Symbolbild) Resistente Bakterien können zum Problem werden. (Symbolbild)

Sie zeigt, dass diese oft tödliche, aber massiv unterdiagnostizierte Infektionskrankheit in Westafrika weiter verbreitet sein könnte als bisher angenommen. Zudem handelt es sich um die größte Serie von Melioidose-Fällen, die jemals in Subsahara-Afrika diagnostiziert wurde.
In einer gemeinsamen Studie von Médecins Sans Frontières/Ärzte ohne Grenzen und der Medizinischen Universität Graz wurden 31 Melioidose-Fälle bei Kindern unter fünf Jahren identifiziert, die in einem einzigen Kinderkrankenhaus in Koutiala, im Süden Malis, behandelt wurden. Die Autor*innen berichten von einer Sterblichkeitsrate von etwa 60 Prozent, was einer Letalität bei Kindern entspricht, wie sie auch in Teilen Südostasiens beobachtet wird, wo die Krankheit endemisch ist.
Ausgelöst durch Bakterien
Melioidose wird durch das in der Umwelt vorkommende Bakterium Burkholderia pseudomallei verursacht. Die Infektion erfolgt in der Regel durch Kontakt mit kontaminiertem Boden oder Wasser, insbesondere während starker Regenfälle. Das klinische Bild ist extrem variabel und reicht von Infektionen der Haut, über Abszesse in inneren Organen und Pneumonien bis hin zur Sepsis. Eine Übertragung von Mensch zu Mensch ist äußerst selten. Während die Krankheit in tropischen Regionen Asiens und des Pazifiks häufig vorkommt und dort alle Altersgruppen - insbesondere ältere Menschen - betrifft, galt sie in Afrika lange als selten. Dies ist vermutlich auf die eingeschränkten Diagnosemöglichkeiten und die geringe klinische Bekanntheit der Erkrankung zurückzuführen.
Durch genetische Analysen der isolierten Erreger konnte die Studie zeigen, dass in Mali sehr unterschiedliche B. pseudomallei-Stämme vorkommen. "Dies deutet darauf hin, dass der Erreger seit langer Zeit endemisch in der Region ist und nicht erst kürzlich eingeführt wurde", erklärt Sabine Lichtenegger vom Diagnostik- und Forschungsinstitut für Hygiene, Mikrobiologie und Umweltmedizin der Medizinischen Universität Graz. Schätzungen zur jährlichen Inzidenz in der Gesamtbevölkerung deuten zudem darauf hin, dass die Krankheitslast in Mali mit der in den am stärksten betroffenen Regionen Asiens und des Pazifiks vergleichbar sein könnte.
"Unsere Ergebnisse legen nahe, dass Melioidose wahrscheinlich schon seit sehr langer Zeit still und unerkannt in Mali - und möglicherweise in ganz Westafrika - vorkommt", berichtet Ivo Steinmetz, Leiter des Diagnostik- und Forschungsinstituts für Hygiene, Mikrobiologie und Umweltmedizin. "Das könnte nur die Spitze eines viel größeren Eisbergs sein."
Resistenzen als Problem
Da B. pseudomallei von Natur aus gegen viele gängige Antibiotika resistent ist, ist eine laborbestätigte Diagnose entscheidend für eine lebensrettende Behandlung. Allerdings gibt es in den meisten afrikanischen Ländern nur sehr wenige Labore, die den Erreger identifizieren können. Die Studie betont daher den dringenden Bedarf an besserer Diagnostikinfrastruktur, klinischer Schulung und epidemiologischer Überwachung der Erkrankung. Dieser Bedarf wird zusätzlich durch den starken Anstieg von Diabetes in Afrika verschärft, da dieser das Risiko einer Melioidose um das Zwölffache erhöht.
Trotz der hohen Sterblichkeit und der überproportionalen Gefährdung der armen und ländlichen Bevölkerung ist Melioidose bislang nicht auf der Liste der vernachlässigten Tropenkrankheiten (Neglected Tropical Diseases) der Weltgesundheitsorganisation (WHO) aufgeführt. Modellbasierte Schätzungen gehen von bis zu 89.000 Todesfällen weltweit pro Jahr aus - eine Zahl, die mit der von Masern vergleichbar ist.
Forderung nach günstiger Diagnose
Die Autor*innen fordern die Einführung einfacher, kostengünstiger Diagnoseverfahren sowie die Validierung neuer, antikörperbasierter Schnelltests für den Einsatz in afrikanischen Gesundheitseinrichtungen. Ebenso betonen sie die Bedeutung weiterer Forschung, um das gesamte Ausmaß der Krankheit auf dem afrikanischen Kontinent zu erfassen. "Diese Entdeckung sollte ein Weckruf sein", fasst Ivo Steinmetz zusammen.
"Melioidose ist kein Problem, das auf Asien oder Australien beschränkt ist. Sie existiert in Afrika, sie kann tödlich sein, und wir dürfen sie nicht länger übersehen", fährt der Wissenschafter fort. Die Autor*innen der Studie hoffen, dass ihre Ergebnisse dazu beitragen, Melioidose als Neglected Tropical Disease anerkennen zu lassen, und dass dadurch mehr Ressourcen für Diagnostik und Forschung zum Schutz gefährdeter Bevölkerungsgruppen in Afrika und anderen Teilen der Welt verfügbar werden.
Link zur Studie:https://www.sciencedirect.com/science/article/pii/S2214109X25003171?via%3Dihub